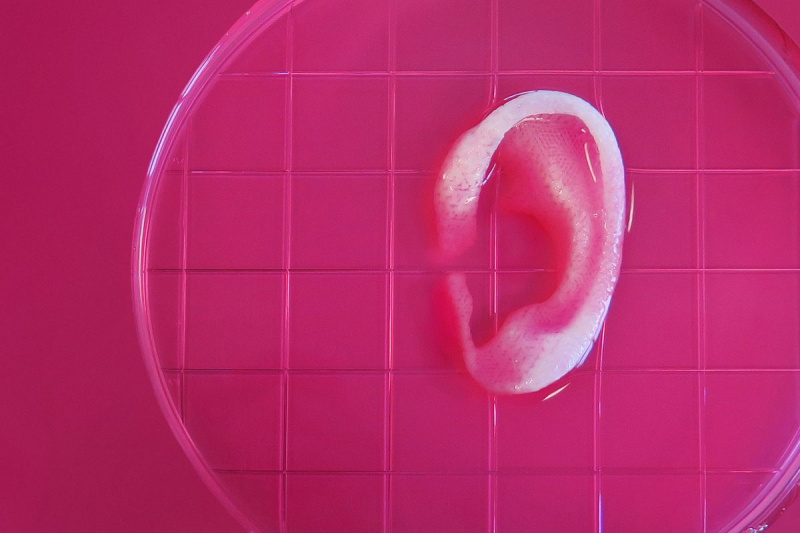
File:3d bio.jpg

File:3d bio.jpg
3d bioprinting
File history
Click on a date/time to view the file as it appeared at that time.
| Date/Time | Thumbnail | Dimensions | User | Comment | |
|---|---|---|---|---|---|
| current | 06:00, 29 January 2020 |  | 1,200 × 800 (83 KB) | Roshan k (Talk | contribs) | (3d bioprinting ) |
- Edit this file using an external application (See the setup instructions for more information)
File usage
There are no pages that link to this file.
Featured articles and news
Repairing historic stone and slate roofs
The need for a code of practice and technical advice note.
UKCW London to tackle sector’s most pressing issues
AI and skills development, ecology and the environment, policy and planning and more.
Managing building safety risks
Across an existing residential portfolio; a client's perspective.
ECA support for Gate Safe’s Safe School Gates Campaign.
Core construction skills explained
Preparing for a career in construction.
Retrofitting for resilience with the Leicester Resilience Hub
Community-serving facilities, enhanced as support and essential services for climate-related disruptions.
Some of the articles relating to water, here to browse. Any missing?
Recognisable Gothic characters, designed to dramatically spout water away from buildings.
A case study and a warning to would-be developers
Creating four dwellings... after half a century of doing this job, why, oh why, is it so difficult?
Reform of the fire engineering profession
Fire Engineers Advisory Panel: Authoritative Statement, reactions and next steps.
Restoration and renewal of the Palace of Westminster
A complex project of cultural significance from full decant to EMI, opportunities and a potential a way forward.
Apprenticeships and the responsibility we share
Perspectives from the CIOB President as National Apprentice Week comes to a close.
The first line of defence against rain, wind and snow.
Building Safety recap January, 2026
What we missed at the end of last year, and at the start of this.